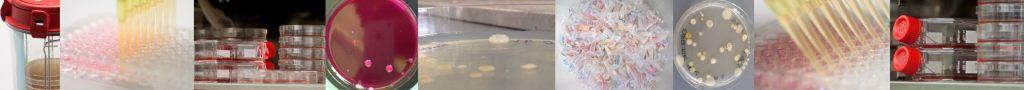

The functional integrity of the human epithelium is crucially important for the protection against intruding pathogens. The cell-adhesion molecule and signaling protein E-cadherin plays a central role in the establishment and maintenance of the epithelial barrier function. We identified a novel bacterial mechanism how bacterial pathogens can efficiently disrupt the epithelial lining through cleavage of the ectodomain of E-cadherin by the secreted bacterial serine protease HtrA (high temperature requirement A). Most research was performed with HtrA expressed by Gram-negative bacteria; however, Gram-positive pathogens express a structurally different class of HtrA proteins. Our preliminary data show that the regulation and functions of HtrA differ considerably between Gram-positive and Gram-negative pathogens while the involved mechanisms are completely unclear. Here, we investigate (i) the activation and substrate specificity of HtrA proteases expressed by selected Gram-positive pathogens and (ii) the functional role of HtrA and E-cadherin truncation in the infection process.

Important publications:
- Abfalter et al., 2019, BMC Microbiol